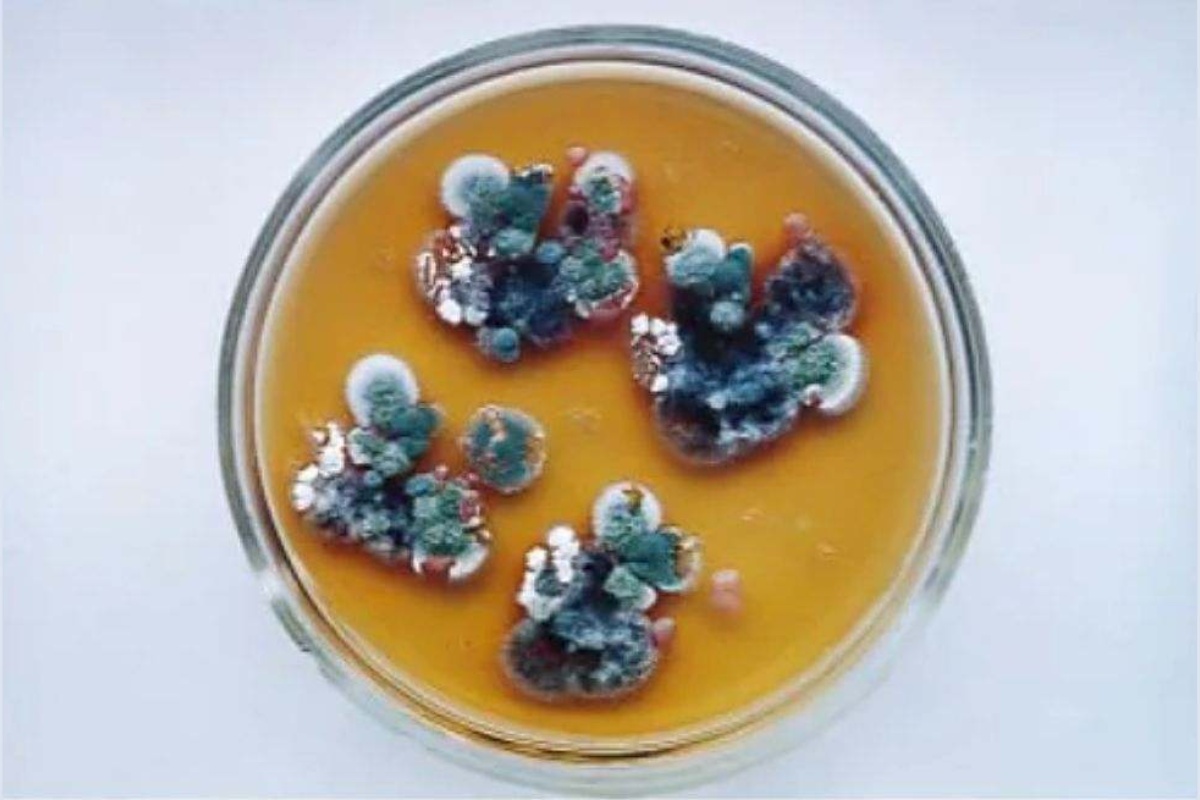
Crna gljiva iz Černobilja koja apsorbuje radijaciju

Naučnici su unutar zabranjene zone u Černobilju identifikovali fascinantan organizam – crnu gljivu koja ne samo da preživljava smrtonosne nivoe zračenja, već ih koristi kao primarni izvor energije. Ovo otkriće iz 2026. godine otvara vrata potpuno novim metodama zaštite, od dekontaminacije nuklearnih postrojenja u Srbiji i svetu, do stvaranja bioloških štitova za astronaute.
Černobiljska katastrofa iz 1986. godine ostavila je iza sebe pustoš, ali je priroda u „Zoni isključenja“ pronašla način da evoluira. Dok je veći deo područja i dalje opasan za ljude, određene vrste gljiva su naselile same zidove uništenog reaktora, hraneći se onim što bi za bilo koje drugo biće bilo kobno.
Radiotrofizam: Mehanizam koji menja nauku
Istraživački tim, koji je predvodila Nelli Zhdanova, primetio je da se ova specifična crna plesan kreće ka izvorima zračenja slično kao što se biljke okreću ka suncu. Fenomen poznat kao radiotrofizam omogućava gljivama da pomoću pigmenta melanina pretvaraju gama zračenje u hemijsku energiju za svoj rast.
- Aktivna potraga: Gljiva bukvalno „lovi“ radioaktivne čestice u okruženju.
- Melanin kao ključ: Visoka koncentracija ovog pigmenta omogućava apsorpciju opasnih talasa.
- Izuzetna otpornost: Uspeva u uslovima gde je nivo radijacije hiljadama puta veći od dozvoljenog.
Od nuklearnog čišćenja do misija na Mars
Potencijal ovog otkrića je ogroman i prevazilazi granice naše planete. Naučna zajednica već razmatra praktičnu primenu ovog biološkog fenomena u nekoliko kritičnih sektora:
1. Biološka dekontaminacija: Korišćenje gljiva za prirodno čišćenje zemljišta i objekata kontaminiranih tokom nuklearnih akcidenata.
2. Zaštita u medicini: Razvoj novih materijala na bazi melanina iz ovih gljiva za zaštitu osoblja koje radi sa rendgenskim i gama zracima.
3. Svemirski štit: Tokom testova na Međunarodnoj svemirskoj stanici (ISS), tanki slojevi ove kulture uspeli su da blokiraju značajan deo kosmičkog zračenja.

Budućnost pod zaštitom živog štita
Naučnici veruju da bi buduće baze na Mesecu i Marsu mogle biti obložene slojevima ovih mikroorganizama. Umesto teških metalnih ploča, astronauti bi mogli da koriste „žive štitove“ koji se sami regenerišu i hrane zračenjem iz svemira. Dok istraživanja traju, crna gljiva iz Černobilja ostaje simbol neverovatne prilagodljivosti života, pretvarajući najveću ljudsku tragediju u izvor tehnološkog napretka za 2026. godinu i decenije koje dolaze.
